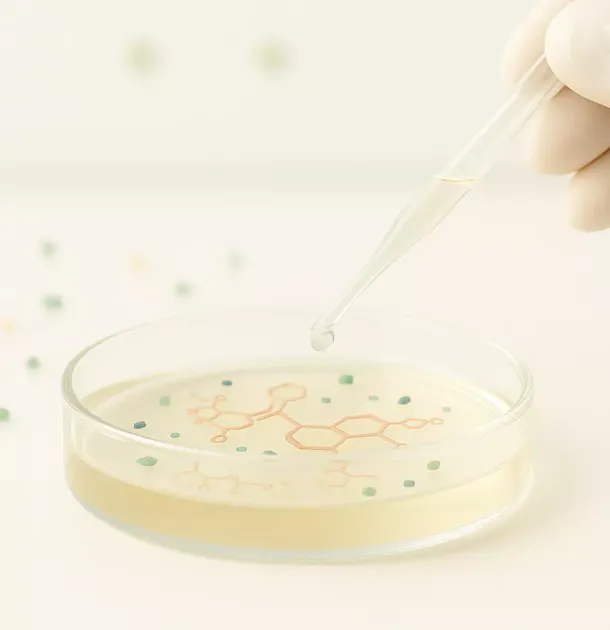

Breaking the Plastic Chain
We investigate the adverse effects of environmental nanoplastics across tissues and during early development by integrating advanced human-relevant models with cutting-edge omics technologies.
The Problem

Beyond visible microplastics, nanoplastics represent an even greater concern because their small size enables them to cross biological barriers, interact with key biomolecules such as proteins, lipids, and DNA, and accumulate in vital organs including the liver and the brain. However, the most realistic and potentially harmful forms—environmentally weathered nanoplastics and the chemicals they release during degradation—remain poorly understood. This critical knowledge gap hampers accurate risk assessment and undermines the development of effective strategies and policies to safeguard human health and the environment.
Our Approach
Environmental nanoplastics
In NanoBreak, we use environmentally derived nanoplastics generated from weathered plastic debris collected along European coasts.
These materials more closely reflect real-life human exposure, as they include not only the particles themselves but also the additives and degradation-derived chemicals released over time.

Advanced biological models
To understand how environmental nanoplastics act in the human body, we use two complementary models achors the 3Rs and New Approach Methodologies (NAMs):
- Human liver organoids – 3D mini-organs derived from induced pluripotent stem cells (iPSCs) that reproduce key features of liver structure and detoxification.
- Zebrafish embryos – A transparent vertebrate model that allows us to study early development, stress responses and potential transgenerational effects.
This dual approach helps us connect cellular and molecular processes with changes at the level of the whole organism.

State-of-the-art tools
The project integrates nanoscale imaging and spatial multi-omics approaches to locate nanoplastics within tissues and identify which biological pathways are altered:
- Spatial metabolomics – Changes in small molecules essential for metabolism.
- Spatial transcriptomics – Which genes are turned on or off in specific tissue regions.
- Spatial epigenomics – Modifications in DNA regulation that may influence long-term effects.
By combining these tools, we can map the journey of nanoplastics inside the body and their biological consequences in unprecedented detail.

Our Approach
Environmental nanoplastics
In NanoBreak, we work with nanoplastics originating from the environment, generated from degraded plastics collected in European coastal areas.
These materials better represent what our bodies are actually exposed to in daily life, including both the particles themselves and the additives and chemical substances released during degradation.

Advanced biological models
To understand how environmental nanoplastics act in the human body, we use two complementary models achors the 3Rs and New Approach Methodologies (NAMs):
- Human liver organoids – 3D mini-organs derived from induced pluripotent stem cells (iPSCs) that reproduce key features of liver structure and detoxification.
- Zebrafish embryos – A transparent vertebrate model that allows us to study early development, stress responses and potential transgenerational effects.
This dual approach helps us connect cellular and molecular processes with changes at the level of the whole organism.

State-of-the-art tools
The project integrates nanoscale imaging and spatial multi-omics approaches to locate nanoplastics within tissues and identify which biological pathways are altered:
- Spatial metabolomics – Changes in small molecules essential for metabolism.
- Spatial transcriptomics – Which genes are turned on or off in specific tissue regions.
- Spatial epigenomics – Modifications in DNA regulation that may influence long-term effects.
By combining these tools, we can map the journey of nanoplastics inside the body and their biological consequences in unprecedented detail.

Objectives

Characterise Environmental
Nanoplastics and their released compounds that are relevant for human exposure.

Assess Their Impact On the Human Liver
Using 3D organoids to study detoxification, stress responses and cellular damage.

Examine Their Effects On Early
Development and potential inheritance of changes using zebrafish embryos.

Identify Key Molecular Pathways
Biomarkers to improve risk assessment and support future regulations.
Objectives

Characterise Environmental
Nanoplastics and their released compounds that are relevant for human exposure.

Assess Their Impact On the Human Liver
Using 3D organoids to study detoxification, stress responses and cellular damage.

Examine Their Effects On Early
Development and potential inheritance of changes using zebrafish embryos.
Identify Key Molecular Pathways
Biomarkers to improve risk assessment and support future regulations.
Impact
NanoBreak will contribute to:


Improving

Supporting

Providing

